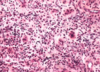

Healing & Repair (pictures) Flashcards
(12 cards)
What is this?
in what condition can you find it?

fibrous scar
MI
what is this condition?
what growth factor receptro is mutated in this condition?

ductal carcinoma
ERB B2 also referred to as (HER-2/Neu)
these 2 pictures are symptoms of what condition?

Osteogenesis Imperfecta
what type of tissue is this?
when this tissue is present, what is it indicative of?
what is it composed of mostly?

Granulation tissue
healing
proliferating capillaries
what type of tissue is this?
granulating tissue
what type of tissue is found in this wound?

granulating
what do we see here?
Liver Cirrhosis: characterized by presence of regenerating nodules and fibrosis
where is this?
what is this?
what cell is dividing in order for this to happen?

brain
tissue repair
astrocytes
what is the problem in this picture?

wound dehiscence
what is the problem here?

formation of keloid scar (scar tissue grows beyond the boundary of the original wound, and do not regress)
what is this picture showing?
what is it?
after what procedure is it common?

Desmoid tumor/ Aggressive fibromatoses
it is interference between normal and malignant proliferation
after cesarean section
what is wrong here?
what is it?

wound contraction
tissue contracts excessively resulting in a deformity


